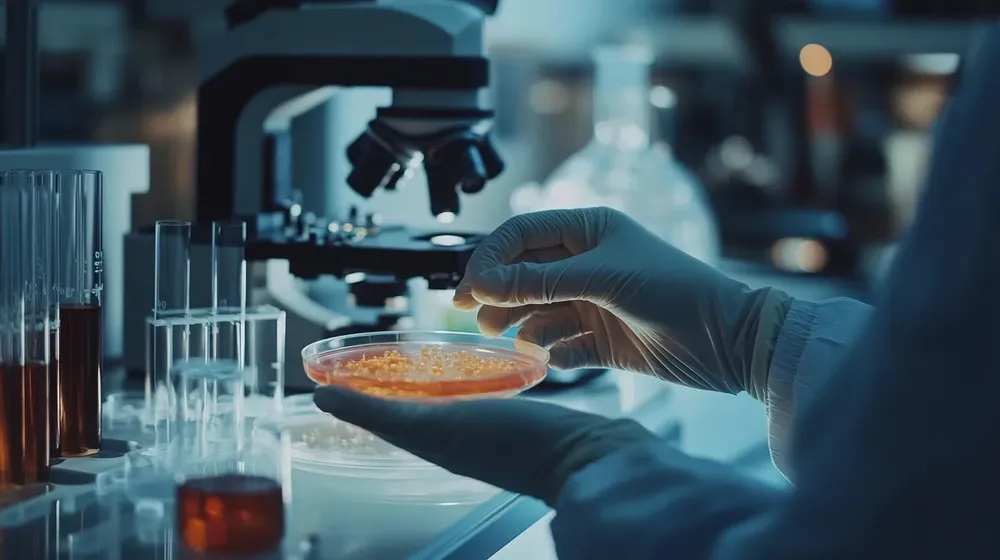

Científicos argentinos lograron visualizar con IA neurorreceptores vinculados a enfermedades neurológicas
NACIONAL27 de septiembre de 2025Esto abre la puerta a una mejor comprensión de cómo las moléculas cambian su comportamiento en respuesta al entorno celular.